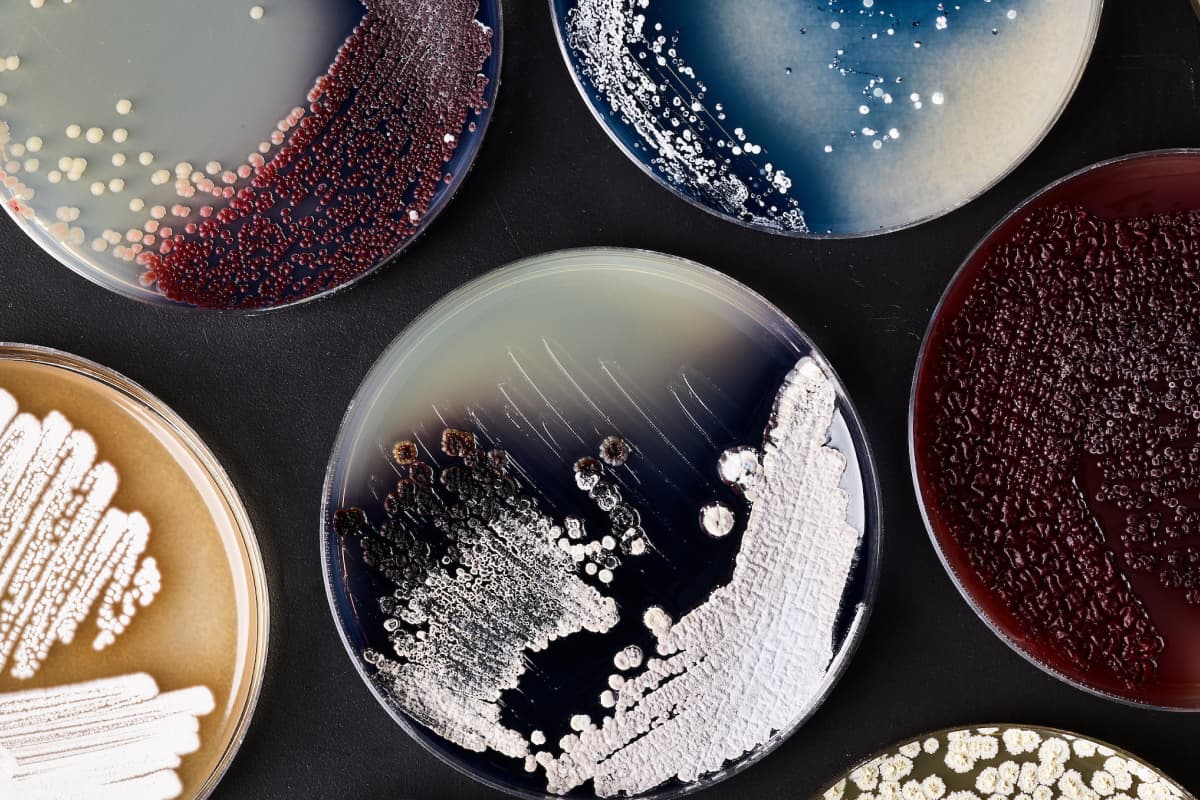

Three Pillars, One Platform
01
Foundry
Our highly automated facility — With over $1 billion invested, our labs feature advanced automation systems, high-throughput screening, and proprietary software that allows us to rapidly design, build, and test engineered cells at an unprecedented scale.
02
Codebase
Our ever-expanding set of genomic data, cells, proteins, models, and knowledge — A vast library of characterized sequences, engineered enzymes, optimized pathways, microbial strains, mammalian cell lines, and AI-driven design tools.
03
People
The power behind the platform — A large, diverse team of scientists, engineers, and experts in cell engineering, automation, analytics, fermentation, and more. Have an R&D challenge you want to discuss? We're here to help.